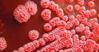
Vi khuẩn ăn thịt người là gì ? Cách phòng tránh bệnh Whitmore bạn cần biết

Chăm sóc người bệnh Alzheimer’s thường rất khó khăn, và nhiều gia đình hoặc bạn bè trông nom người bệnh đã phải trải qua những cảm xúc vô cùng căng thẳng, thậm chí dẫn đến trầm cảm. Mặc dù các nhà nghiên cứu không biết chính xác nguyên nhân hay phát triển của căn bệnh này, nhưng họ nhận ra rằng có một số loại thực phẩm và chất dinh dưỡng có ảnh hưởng tới bệnh Alzheimer. Có nhiều nghiên cứu đã chỉ ra rằng có một liên kết và ảnh hưởng khá rõ ràng giữa chế độ ăn uống và sự phát triển của bệnh.
Dưới đây là 10 cách làm giảm nguy cơ và tốc độ của bênh đã được các nhà khoa học nghiên cứu và khuyên làm theo.
Giảm thiểu đường trong khẩu phần ăn hàng ngày
Đây là một trong những điều quan trọng nhất mà các nhà khoa học cảnh báo. Nhiều nghiên cứu đã chứng minh đường là thức ăn quan trọng của các chứng viêm, đặc biệt là trong não. Bạn vẫn nên duy trì lượng đường nạp vào cơ thể hàng ngày lý tưởng nhất là ít hơn 25 gram mỗi ngày. Trong một thí nghiệm trên động vật trong phòng thí nghiệm, một chế độ ăn chứa nhiều đường làm cho bộ nhớ của chúng khiếm khuyết chỉ sau 7 ngày!

Đường là một trong những nguyên nhân gây ra bệnh mất trí nhớ
Bổ sung sắt
Một chế độ ăn nhiều sắt sẽ giúp bạn chống lại các bệnh mất trí nhớ một cách hiệu quả. Rau màu xanh đậm được coi là nguồn bổ sung sắt hiệu quả và dễ dàng nhất trong thực đơn ăn uống hàng ngày.
Bổ sung thêm chất béo lành mạnh
Chất béo lành mạnh bao gồm các axit béo omega-3 trong cá, bơ hữu cơ từ sữa tươi, ô liu, dầu ôliu nguyên chất và dầu dừa, bơ, và các loại hạt như quả hồ đào và hạt mắc ca…
Giảm thiểu sự nhiễm độc kim loại
Ngộ độc kim loại nặng là một trong những tác nhân nguy hiểm làm triển bệnh Alzheimer. Bạn có thể tránh các kim loại nặng bằng cách loại bỏ các chất hàn răng có chứa kim loại, tránh sử dụng dụng cụ nấu nhôm, đồ nhôm, lon nhôm hoặc thùng chứa, chai rượu nhôm, và chất chống mồ hôi có chứa nhôm… để tránh cho kim loại này tích tụ trong cơ thể.
Tập thể dục thường xuyên
Một số nghiên cứu cho thấy rằng tập thể dục thường xuyên có thể tạo ra những thay đổi trong chuyển hoá của các protein amyloid tiền chất. Điều này sẽ giúp làm chậm sự tiến triển của bệnh Alzheimer. Bạn chỉ cần đi bộ 30 phút mỗi ngày hoặc 5-6 ngày một tuần để duy trì sự đều đặn này.

Tập thể dục thường xuyên giúp phòng tránh nhiều bệnh tật
Tránh các loại vắc-xin có chứa thủy ngân
Tiêm phòng các bệnh bằng vắc-xin là điều nên làm do có rất nhiều căn bệnh hiểm nghèo mà cơ thể chúng ta không tự phòng tránh được. Tuy nhiên, hãy tìm hiểu và chắc chắn rằng những vắc-xin này không chứa thủy ngân để tránh sự nhiễm độc ảnh hưởng không tốt tới trí óc của bạn.
Tránh sử dụng các loại thuốc an thần
Nếu bạn phải dùng thuốc an thần, bạn nên tham khảo ý kiến bác sĩ, vì các loại thuốc này có thể gây ra chứng mất trí như thuốc kháng histamin, thuốc chống trầm cảm, thuốc giảm đau, thuốc ngủ. Trong đó có thuốc Statin được xem là nguy hiểm nhất vì nó có thể làm chậm sự tổng hợp cholesterol, phá hủy các chất dẫn truyền thần kinh và coenzyme Q10. Điều này ngăn cản việc cung cấp đủ lượng chất chống oxy hóa tan trong chất béo và các axit béo thiết yếu cho cơ thể bạn. Tốt nhất là bạn nên tìm những liệu pháp trị kiệu khác để thay thế thuốc.
Luyện tập trí não hàng ngày
Các nghiên cứu đã chỉ ra rằng, tập luyện cho não hàng ngày là một trong những cách hiệu quả để cải thiện trí nhớ cũng như đẩy lùi bệnh Alzheimer. Bạn có thể kích thích não bằng cách học hỏi những điều mới, chẳng hạn như học một ngôn ngữ mới hoặc cách chơi một nhạc cụ mới, đã được chứng minh có liên quan với nguy cơ thấp hơn nhiều của bệnh Alzheimer. Các nhà nghiên cứu tin rằng cách này sẽ giúp bộ não của bạn mạnh mẽ hơn, ít nhạy cảm hơn với các tổn thương có liên quan với chứng mất trí và bệnh Alzheimer.
Bổ sung vitamin D cho cơ thể
Lượng vitamin trong máu quá thấp là một trong những điều ảnh hưởng tới bệnh Alzheimer. Các nghiên cứu cho thấy vitamin D làm tăng lượng hóa chất trong não bộ và bảo vệ các tế bào não. Vitamin D là một tự nhiên chống viêm và có các hợp chất xây dựng hệ miễn dịch, mà sự viêm nhiễm lại được biết đến là một trong những nguyên nhân chính của bệnh Alzheimer. Nếu không quen với việc tắm nắng, bạn có thể bắt đầu từ 5 phút/ngày rồi tăng dần lên 30-35 phút dưới ánh nắng nhẹ. Ngoài ra, bạn cũng có thể bổ sung vitamin D bằng các thực phẩm chức năng hay các viên uống tổng hợp.
Có giấc ngủ ngon
Sức khỏe não bộ sẽ tăng lên nếu như bạn tạo cho mình những giấc ngủ ngon và chất lượng. Cách duy nhất để có một giấc ngủ ngon là tạo thói quen ngủ đúng giờ và ngủ đủ giấc, không ngủ quá ít cũng không quá nhiều. Trung bình một người nên ngủ vào ban đêm từ 7 – 9 tiếng/ngày. Đặc biệt không nên ngủ trưa, ngủ trưa nhiều sẽ gây cản trở cho giấc ngủ vào ban đêm và điều này về lâu dài sẽ thành cái vòng luẩn quẩn.
Thu Hương
(Tổng hợp)
Websosanh.vn – Website so sánh giá đầu tiên tại Việt Nam